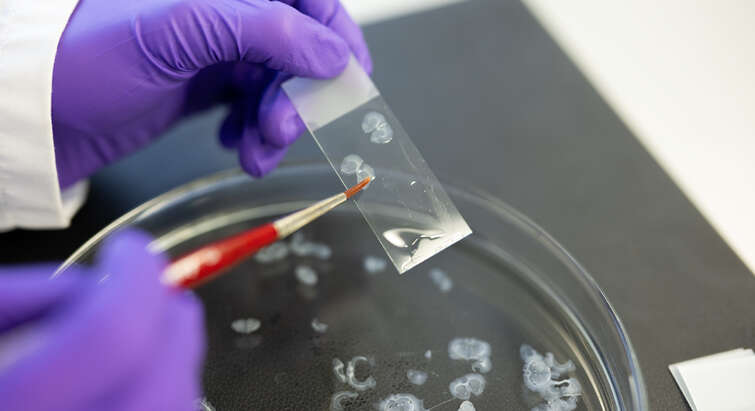

Transforming lives with stem cell medicine
Our aim is to develop an international targeted research center delivering innovative stem cell-driven therapies to transform the lives of people suffering from incurable disease.
reNEW is dedicated to addressing both childhood and adult diseases. This encompasses:
- stem cell-based cellular therapies and regenerative medicine
- novel therapies identified via the use of human stem cell-derived tissue models
- gene editing to correct disease associated mutations